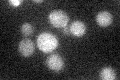
YLR356W
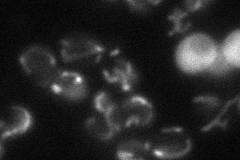
YLR356W
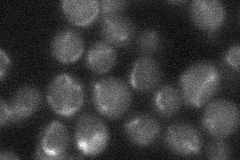
YLR356W
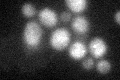
YLR356W
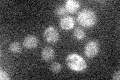
YLR356W

View description
Mitochondrial mitophagy-specific protein; required primarily for mitophagy induced at the post-log phase; not required for other types of selective autophagy or macroautophagy; conserved within fungi, but not in higher eukaryotes
Localization:
Intensity:
Fold change:
Significance:
-
C’ GFP library in SD
below threshold16.64 -
N' NOP1pr-GFP in SD

mitochondria42.7207 -
N' TEF2pr-mCherry in SD
mitochondria22.5548 -
N' NATIVEpr-GFP in SD
mitochondria22.9599 -
N' TEF2pr-VC and Cyto-VN in SD

below threshold23.5298 -
C’ GFP library in SD+DTT
cytosol17.061.02No -
C’ GFP library in SD+H2O2

cytosol16.050.96No -
C’ GFP library in Starvation Media
cytosol18.091.08No -
C’ GFP library on the background of Pup2-DaMP

below threshold -
C’ GFP library on the background of CCT mutant

below threshold15.51030.931378No
